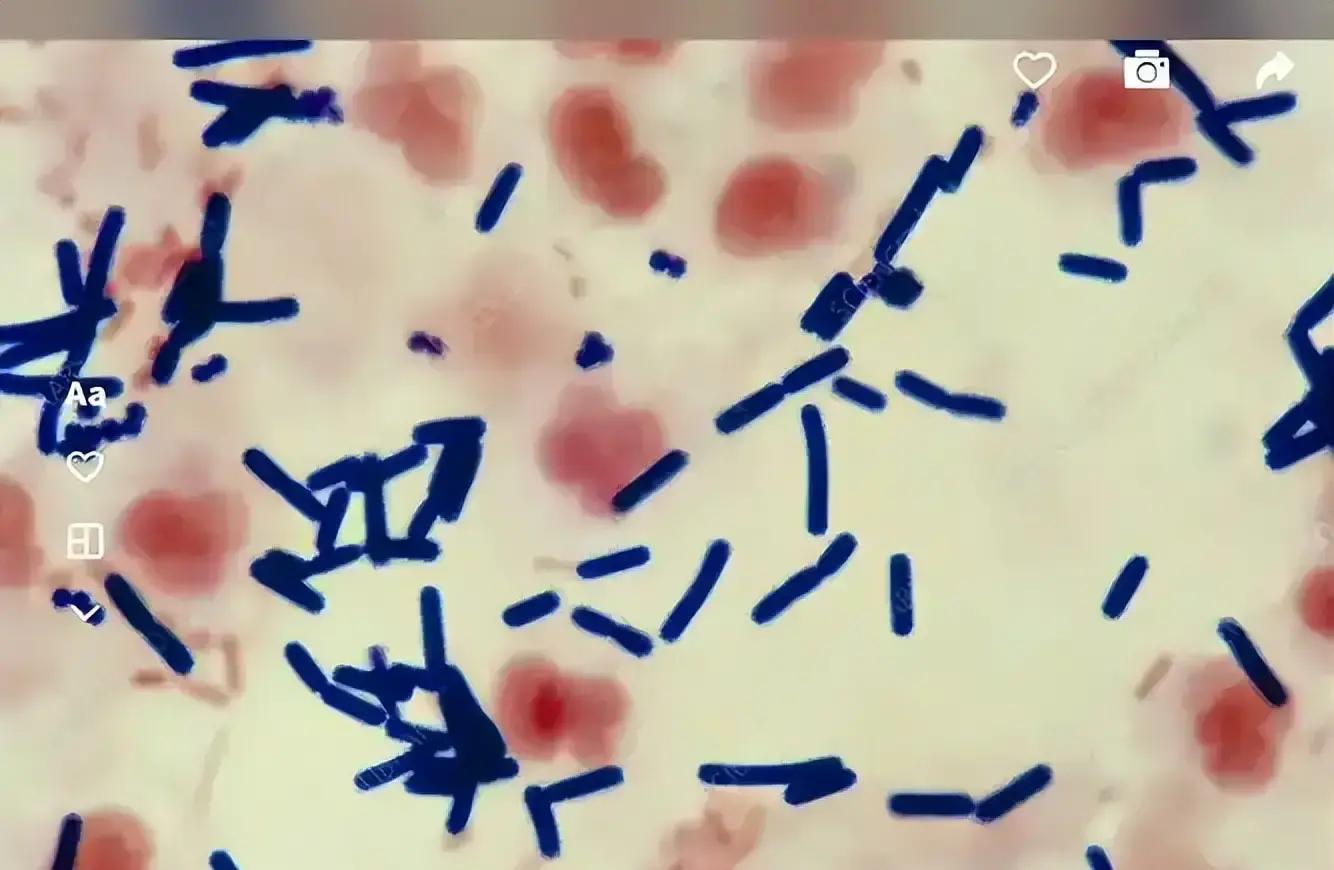
健身需要带手套吗_气性坏疽 手套防护 体力劳动者安全

汗汗画画免费阅读在线阅读下拉式 一定要戴手套!43岁男子8天离世,死亡率近100%:你我都在
谁能料想,一位年逾不惑之人韩漫漫画网站免费观看下拉式,头一日尚于家中肩负水泥,次周陡然径直迈入了重症加强护理病房呢。
不是那种从高处一跃而下的蹦极,也不是风驰电掣般的飙车,更不是所谓命里犯了小人这般玄乎的事,而是在搬移物品的时候,手上出现了一道被铁丝划出来的痕迹。并没有流出几滴血液,用消毒水轻轻一抹,之后搬完东西便继续去喝酒撸串了。活到如今这样的岁数,皮肤擦破点皮的状况谁又没有碰到过呢?大家都认为这属于是小伤口,又能发生什么事情呢。我就是不信这个邪。

结果,八天之后,硬汉子走了。全家直接懵了。
医院给出的结论,甚是扎心,那便是气性坏疽,好多人或许未曾听闻,听起来仿若是什么空气方面的感染,或者肺部的严重病症,与新冠毫无关联,二者相差甚远,毫无联系 。
能够在实际当中,这等事物的毒性相比新冠而言还要更为邪乎,一旦患上之后,骨头以及血肉在所说的情况下就会迅速溃烂,根本不会给予你第二次的任何机会。
刨根究底来讲,它是一种名为产气荚膜梭菌的陈旧货色,像在地里,在石头缝隙之中,于锈迹斑斑的铁制品上面,都能寻觅到它众多的身影。

许多之人下意识抛却一句——“农村病”,城里之人尚觉高枕并无忧虑,家中洁净便以为即安全,若如此去想,迟早会碰到“社会人”,于厨房切菜之时却切中了手,下水道需修理渗漏之处,更换灯泡之际划破了皮,甚至开车门之时不小心撞破了些许,怎能够确保是百分百的干净呢?
玩笑说得难听点,想到切盘苹果染上这病,估计谁都吃不下饭。

实际上患有此病症,存在三个步骤。其一,皮肤出现破损状况。其二,脏污之物进入。其三,所处位置血液较少秘密教学漫画完整版免费阅读看下拉式笔趣阁简体,细菌进入后兴奋得飘飘然 。
体质好、经常锻炼,管啥用?真惹着它了,撒丫子跑都晚了。
将其改写为:医生最为惧怕的便是“没事观望”这种情况,在前期的时候并没有什么特别突出的表现,只是出现红肿之感,伴有疼痛,然而还能够忍受得住,一直熬到体温急剧飙升至极高程度,毒素在全身各处游动,任凭何种药物都已拦下不住,那些症状更为严重之人,会出现失去意识的状况,各个器官接连不断地出现故障,转瞬之间人就已经到了无法抢救的地步 。
那么,难道是药没有起到应有的作用,医院也存在着问题吗?并非如此。只是这个事物的发展速度实在是太快了,快到如同跑表计时一般。致使所有医生以及家属的心理压力都急剧飙升至顶点,明明从道理上讲是应该能够挽救的,然而其进展速度过快,一旦有一步赶不上,就会导致步步落后。
其实,办法着实挺朴素的 是干体力活之际就戴上手套 然而这句却被太多人当作笑话来听 像装修的时候 搬家的时候 修车的时候 甚至插花的时候 家里做饭的时候 戴上一副手套 谁要是爱干净谁就戴 因怕麻烦 怕被人笑话 还想省个几块钱 可结局并非是省事 它是能够挡住百分之八十的坏事的。
难道您不晓得yy漫画画免费读漫画下拉式阅读网页,您发问戴手套究竟有啥困难之处吗,扔掉垃圾之时需要佩戴,烹饪之时需要佩戴,钉钉子之时同样亦要佩戴,不然又能如何,难道生命当真会比这仅仅价值两块钱的塑胶手套还要显得不值钱吗 ?
回过头去看好多案子,病着的人里头大多数是那种纠结着、犹豫着,一直拖到实在再也熬不过去了才去到医院的。有一些人在最开始的时候还会劝着说“忍一忍就会好起来的”,等到细菌都已经开始蔓延开来的时候就已经没有别的退路可走了。
朋友圈热衷于转发“健康忠告”,然而却轻视这种提醒,结果当事情真切地发生在自己头上时,谁都不要去说啥“后悔没用” 。
不存在丝毫多余话语:手套并非是为讲究卫生,而是用来抵挡性命之危。家中动手做事较多之人,老人进行劳作的,年轻人从事高风险工作的,都理应准备一打。
绝不能有这样一种情况,使得仅仅一个手套,就致使档口生意遭受断送,并且也绝不应该有一种情形,让一条小小的伤口,导致活生生的人走向葬送的结局。
身边爱逞能、总说“我没事”,“男人不在乎疤”,都该瞪大眼。
谁知道呢?
鲁ICP备18019461号-4
我要评论